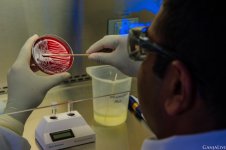
87b-CBD-show-up-on-drug-tests.jpg

CBD - это растущая тенденция к здоровью. Это одно из популярных и эффективных лечебных трав, которое вошло в основную натуральную медицину. CBD обращается к ряду энтузиастов, но из-за его тесной связи с каннабисом люди все еще задают вопросы: обнаруживается ли CBD на тестах на наркотики?
Перво-наперво, что такое CBD?
Каннабидиол, обычно называемый CBD, представляет собой естественное соединение, обнаруженное в цветках растения каннабис. До сегодняшнего дня каннабис известен как большое количество разнообразных лекарственных растений. Лечебные свойства исследуются и подтверждаются учеными всего мира. CBD отмечен Всемирной организацией здравоохранения как безопасное, нетоксичное и не вызывающее привыкания вещество. Это один из 100+ «фитоканнабиноидов», уникальных для каннабиса, что придает растению его терапевтический профиль.
CBD - это альтернативное лечение хронической боли, беспокойства, воспаления, депрессии и многих других тяжелых состояний, если традиционная медицина не помогает. Исследования также доказали, что CBD обладает нейропротекторным действием и противораковыми свойствами. Благодаря соответствующим исследованиям и анекдотам людей, которые верят в терапевтические преимущества CBD, CBD изменил терапевтический ландшафт и изменил общественное восприятие каннабиса.
Масла и добавки CBD обычно получают из цветов промышленных растений конопли. Хотя CBD в изобилии и является основным веществом в шишках, следы небольшого количества THC все же вероятны. Большая часть масла CBD содержит 0,3% THC; это максимальное количество THC, которое разрешено содержать в лечебных маслах. Это незначительная сумма, и она не может поднять эйфорический эффект у пользователей. Но обнаружатся ли следы ТГК при тестировании на наркотики?
Однозначный ответ - нет. Для лучшего понимания давайте сначала обсудим, что такое THC и чем он отличается от CBD. Оттуда давайте углубимся в то, почему CBD не обнаруживается на тестах на наркотики.
CBD против THC:
ТГК и КБД - это фитоканнабиноиды, полученные из растения марихуаы, но они во многом отличаются друг от друга: они могут влиять на ваши чувства и мысли. Легко объяснить это тем, что THC обладает психоактивной эффективностью, а CBD - нет.
ТГК является психоактивным компонентом каннабиса, что означает, что он отвечает за создание «кайфа», связанного с употреблением каннабиса. THC связывается с рецепторами CB1 эндоканнабиноидной системы (ECS). Этих рецепторов много в головном и спинном мозге, и когда ТГК их стимулирует, он оказывает психотропные или изменяющие сознание эффекты.
Терапевтический потенциал ТГК впечатляет и широк. Он может действовать как против тошноты, стимулятора аппетита, снотворного, противовоспалительного, миорелаксанта, обезболивающего, антиоксиданта и многих других. Большинству людей ТГК нравится не только из-за его медицинских преимуществ, но и из-за ощущения, которое он дает.
CBD, с другой стороны, не связывается с рецепторами CB1 ECS. Из-за этого продукты CBD, даже с малым количеством THC, сдерживают психотропные эффекты THC, подавляя его способность связывать и стимулировать рецепторы CB1. Вот почему люди не чувствуют «кайфа» при использовании CBD по сравнению с теми, кто потребляет продукты с высоким содержанием THC. Итак, если вам нужны терапевтические преимущества каннабиса без эйфорического эффекта, CBD - это ключ. CBD также предлагает широкий спектр лечебных преимуществ, не вызывая у пользователей приподнятого настроения. Это может быть противовоспалительное, анксиолитическое и антипсихотическое средство, успокаивающее, нейропротекторное, противосудорожное, противоопухолевое, болеутоляющее, иммуномодулятор и многое другое.
Существует два основных типа тестов на наркотики: на 5-видов и на 10 видов наркотиков. 5-видовые тестовые экраны на кокаин, опиаты, PCP, амфетамины / метамфетамины и THC. Тестовые экраны для 10 видов упомянутых выше наркотиков и еще пяти рекреационных наркотиков. Как вы, возможно, заметили, CBD не входит в список лекарств, проверяемых на наркотики. Это потому, что CBD не вреден и не вызывает привыкания. Но поскольку продукты CBD содержат следовые количества THC, вы все равно можете задаться вопросом, есть ли вероятность, что использование CBD может привести к положительному результату теста на наркотики.
Получу ли я положительный результат теста на наркотики при употреблении CBD?
CBD не обнаруживается при тестировании на наркотики. Тесты на наркотики специально ищут признаки ТГК. Тест на наркотики измеряет уровень метаболитов THC в организме. Этот метаболит обнаруживается через 90 дней после употребления. Некоторые продукты CBD вообще не содержат THC. Они известны как изоляты CBD или CBD широкого спектра действия, и они не будут обнаружены в тестах на наркотики.
Есть продукты CBD, которые содержат следы небольшого количества THC, маркированные как CBD полного спектра. По закону они должны содержать не более 0,3% THC. Итак, как насчет 0,3% THC в вашем CBD? Положит ли это тест на наркотики?
Ответ однозначный: нет.
CBD со следами небольшого количествами THC не даст положительного результата теста на наркотики. Для получения положительных результатов теста на наркотики необходимо соблюдать определенные пороговые значения. Министерство здравоохранения и социальных служб установило предельные значения ТГК для тестирования на наркотики на рабочем месте, чтобы указать на присутствие наркотиков в организме человека. Порог варьируется в зависимости от типа теста:
Моча: для получения положительного результата теста на наркотики необходимо 50 нанограммов на миллилитр ТГК. Продукты, насыщенные CBD, не демонстрируют это количество с 0,3% THC или меньше. Хотя высокие дозы CBD (1-2 г + в день) могут вызвать «ложноположительный» анализ мочи. Но повторный анализ ГХ / МС не будет введен в заблуждение и все равно даст отрицательный результат.
Волосяной фолликул: это относительно новый метод тестирования на наркотики. Он может обнаружить присутствие THC еще 90 дней назад. Один пикограмм на миллиграмм THC необходим для начального скрининга и 0,05 пикограмма THC для подтверждающего тестирования.
Кровь: этот тест встречается редко, потому что ТГК выводится из кровотока быстро после употребления. Для этого метода тестирования не существует стандартизированного порога содержания ТГК, но Колорадо и Вашингтон установили пять нанограммов на миллилитр в качестве порогового значения для вождения в нетрезвом виде.
Слюна: этот метод тестирования менее распространен, чем моча, и еще не установлено пороговое значение для ТГК. Предлагаемый порог составляет четыре нанограмма на миллилитр ТГК для первоначального скрининга и два нанограмма на миллилитр ТГК для подтверждающего тестирования.
Есть ли способы, которыми CBD может заставить вас не пройти тест на наркотики?
CBD не будет обнаруживаться в тестах на наркотики, но все еще есть много факторов, которые могут привести к положительному результату теста на наркотики. Есть несколько причин, по которым пользователь CBD может не пройти тест на наркотики.
Неправильная маркировка
Однако большинство продуктов CBD не контролируются и не регулируются Управлением по контролю за продуктами и лекарствами (FDA). Из-за этого сложно понять, что внутри них. FDA не оценивает точность информации о продукте. Продукты, содержащие CBD, могут иметь неправильную маркировку. На этикетках может быть указано, что продукт содержит только 0,3% THC, но это не всегда так.
Перекрестное загрязнение THC
THC может попасть в продукты CBD через перекрестное загрязнение. Такая ситуация возникает, когда производитель не уделяет пристального внимания процессам выращивания, сбора урожая, извлечения и производства.
CBD, полученный из марихуаны с высоким содержанием ТГК
Существует разница между CBD, полученным из концентрата конопли и марихуаны. Если вы используете CBD, полученный из выжимки марихуаны, они могут содержать много THC, и более вероятно, что вы получите положительный результат теста на наркотики.
Пассивное воздействие ТГК
Пассивное употребление марихуаны может дать положительный результат теста на наркотики слюны и волос. Это зависит от того, сколько ТГК вы усвоили из-за пассивного курения, и от активности марихуаны.
Поскольку CBD не регулируется должным образом, нет гарантии, что продукт, который вы покупаете или в настоящее время используете, содержит чистое масло CBD или что его концентрация находится на безопасном уровне. Лучше всего проявлять особую осторожность и провести обширные исследования при покупке продукта CBD, чтобы обеспечить его безопасность и чистоту, особенно если вам нужно пройти тесты на наркотики.
Какие самые безопасные варианты?
Теперь, когда вы знаете, что даже если CBD не будет обнаружен на тестах на наркотики, все еще есть риски неудачи, вам следует научиться снижать этот риск. Если вы принимаете CBD для снятия боли, депрессии, беспокойства и других состояний здоровья, вы не заслуживаете положительного результата теста на наркотики.
Вы можете ограничить риск получения «ложного срабатывания», покупая продукты CBD только в надежных компаний. Не выбирайте дешевые продукты CBD, потому что есть вероятность; они содержат THC и другие химические вещества. Изучите продукт, который вы покупаете, и убедитесь, что он содержит нужное количество THC. Убедитесь, что продукт был протестирован сторонней лабораторией и имеет сертификат анализа (COA), аккредитованный товаром. Он должен иметь сертификат анализа (COA), выданный лабораториями, сертифицированными одной из этих организаций: Ассоциацией официальных сельскохозяйственных химиков (AOAC), Американской фармакопеей трав (AHP) или Фармакопеей США (USP).
CBD предлагает отличные медицинские преимущества, и вам не следует кататься на коньках по тонкому льду, покупать дешевые CBD и проваливать тест на наркотики.
Перво-наперво, что такое CBD?
Каннабидиол, обычно называемый CBD, представляет собой естественное соединение, обнаруженное в цветках растения каннабис. До сегодняшнего дня каннабис известен как большое количество разнообразных лекарственных растений. Лечебные свойства исследуются и подтверждаются учеными всего мира. CBD отмечен Всемирной организацией здравоохранения как безопасное, нетоксичное и не вызывающее привыкания вещество. Это один из 100+ «фитоканнабиноидов», уникальных для каннабиса, что придает растению его терапевтический профиль.
CBD - это альтернативное лечение хронической боли, беспокойства, воспаления, депрессии и многих других тяжелых состояний, если традиционная медицина не помогает. Исследования также доказали, что CBD обладает нейропротекторным действием и противораковыми свойствами. Благодаря соответствующим исследованиям и анекдотам людей, которые верят в терапевтические преимущества CBD, CBD изменил терапевтический ландшафт и изменил общественное восприятие каннабиса.
Масла и добавки CBD обычно получают из цветов промышленных растений конопли. Хотя CBD в изобилии и является основным веществом в шишках, следы небольшого количества THC все же вероятны. Большая часть масла CBD содержит 0,3% THC; это максимальное количество THC, которое разрешено содержать в лечебных маслах. Это незначительная сумма, и она не может поднять эйфорический эффект у пользователей. Но обнаружатся ли следы ТГК при тестировании на наркотики?
Однозначный ответ - нет. Для лучшего понимания давайте сначала обсудим, что такое THC и чем он отличается от CBD. Оттуда давайте углубимся в то, почему CBD не обнаруживается на тестах на наркотики.
CBD против THC:
ТГК и КБД - это фитоканнабиноиды, полученные из растения марихуаы, но они во многом отличаются друг от друга: они могут влиять на ваши чувства и мысли. Легко объяснить это тем, что THC обладает психоактивной эффективностью, а CBD - нет.
ТГК является психоактивным компонентом каннабиса, что означает, что он отвечает за создание «кайфа», связанного с употреблением каннабиса. THC связывается с рецепторами CB1 эндоканнабиноидной системы (ECS). Этих рецепторов много в головном и спинном мозге, и когда ТГК их стимулирует, он оказывает психотропные или изменяющие сознание эффекты.
Терапевтический потенциал ТГК впечатляет и широк. Он может действовать как против тошноты, стимулятора аппетита, снотворного, противовоспалительного, миорелаксанта, обезболивающего, антиоксиданта и многих других. Большинству людей ТГК нравится не только из-за его медицинских преимуществ, но и из-за ощущения, которое он дает.
CBD, с другой стороны, не связывается с рецепторами CB1 ECS. Из-за этого продукты CBD, даже с малым количеством THC, сдерживают психотропные эффекты THC, подавляя его способность связывать и стимулировать рецепторы CB1. Вот почему люди не чувствуют «кайфа» при использовании CBD по сравнению с теми, кто потребляет продукты с высоким содержанием THC. Итак, если вам нужны терапевтические преимущества каннабиса без эйфорического эффекта, CBD - это ключ. CBD также предлагает широкий спектр лечебных преимуществ, не вызывая у пользователей приподнятого настроения. Это может быть противовоспалительное, анксиолитическое и антипсихотическое средство, успокаивающее, нейропротекторное, противосудорожное, противоопухолевое, болеутоляющее, иммуномодулятор и многое другое.
Существует два основных типа тестов на наркотики: на 5-видов и на 10 видов наркотиков. 5-видовые тестовые экраны на кокаин, опиаты, PCP, амфетамины / метамфетамины и THC. Тестовые экраны для 10 видов упомянутых выше наркотиков и еще пяти рекреационных наркотиков. Как вы, возможно, заметили, CBD не входит в список лекарств, проверяемых на наркотики. Это потому, что CBD не вреден и не вызывает привыкания. Но поскольку продукты CBD содержат следовые количества THC, вы все равно можете задаться вопросом, есть ли вероятность, что использование CBD может привести к положительному результату теста на наркотики.
Получу ли я положительный результат теста на наркотики при употреблении CBD?
CBD не обнаруживается при тестировании на наркотики. Тесты на наркотики специально ищут признаки ТГК. Тест на наркотики измеряет уровень метаболитов THC в организме. Этот метаболит обнаруживается через 90 дней после употребления. Некоторые продукты CBD вообще не содержат THC. Они известны как изоляты CBD или CBD широкого спектра действия, и они не будут обнаружены в тестах на наркотики.
Есть продукты CBD, которые содержат следы небольшого количества THC, маркированные как CBD полного спектра. По закону они должны содержать не более 0,3% THC. Итак, как насчет 0,3% THC в вашем CBD? Положит ли это тест на наркотики?
Ответ однозначный: нет.
CBD со следами небольшого количествами THC не даст положительного результата теста на наркотики. Для получения положительных результатов теста на наркотики необходимо соблюдать определенные пороговые значения. Министерство здравоохранения и социальных служб установило предельные значения ТГК для тестирования на наркотики на рабочем месте, чтобы указать на присутствие наркотиков в организме человека. Порог варьируется в зависимости от типа теста:
Моча: для получения положительного результата теста на наркотики необходимо 50 нанограммов на миллилитр ТГК. Продукты, насыщенные CBD, не демонстрируют это количество с 0,3% THC или меньше. Хотя высокие дозы CBD (1-2 г + в день) могут вызвать «ложноположительный» анализ мочи. Но повторный анализ ГХ / МС не будет введен в заблуждение и все равно даст отрицательный результат.
Волосяной фолликул: это относительно новый метод тестирования на наркотики. Он может обнаружить присутствие THC еще 90 дней назад. Один пикограмм на миллиграмм THC необходим для начального скрининга и 0,05 пикограмма THC для подтверждающего тестирования.
Кровь: этот тест встречается редко, потому что ТГК выводится из кровотока быстро после употребления. Для этого метода тестирования не существует стандартизированного порога содержания ТГК, но Колорадо и Вашингтон установили пять нанограммов на миллилитр в качестве порогового значения для вождения в нетрезвом виде.
Слюна: этот метод тестирования менее распространен, чем моча, и еще не установлено пороговое значение для ТГК. Предлагаемый порог составляет четыре нанограмма на миллилитр ТГК для первоначального скрининга и два нанограмма на миллилитр ТГК для подтверждающего тестирования.
Есть ли способы, которыми CBD может заставить вас не пройти тест на наркотики?
CBD не будет обнаруживаться в тестах на наркотики, но все еще есть много факторов, которые могут привести к положительному результату теста на наркотики. Есть несколько причин, по которым пользователь CBD может не пройти тест на наркотики.
Неправильная маркировка
Однако большинство продуктов CBD не контролируются и не регулируются Управлением по контролю за продуктами и лекарствами (FDA). Из-за этого сложно понять, что внутри них. FDA не оценивает точность информации о продукте. Продукты, содержащие CBD, могут иметь неправильную маркировку. На этикетках может быть указано, что продукт содержит только 0,3% THC, но это не всегда так.
Перекрестное загрязнение THC
THC может попасть в продукты CBD через перекрестное загрязнение. Такая ситуация возникает, когда производитель не уделяет пристального внимания процессам выращивания, сбора урожая, извлечения и производства.
CBD, полученный из марихуаны с высоким содержанием ТГК
Существует разница между CBD, полученным из концентрата конопли и марихуаны. Если вы используете CBD, полученный из выжимки марихуаны, они могут содержать много THC, и более вероятно, что вы получите положительный результат теста на наркотики.
Пассивное воздействие ТГК
Пассивное употребление марихуаны может дать положительный результат теста на наркотики слюны и волос. Это зависит от того, сколько ТГК вы усвоили из-за пассивного курения, и от активности марихуаны.
Поскольку CBD не регулируется должным образом, нет гарантии, что продукт, который вы покупаете или в настоящее время используете, содержит чистое масло CBD или что его концентрация находится на безопасном уровне. Лучше всего проявлять особую осторожность и провести обширные исследования при покупке продукта CBD, чтобы обеспечить его безопасность и чистоту, особенно если вам нужно пройти тесты на наркотики.
Какие самые безопасные варианты?
Теперь, когда вы знаете, что даже если CBD не будет обнаружен на тестах на наркотики, все еще есть риски неудачи, вам следует научиться снижать этот риск. Если вы принимаете CBD для снятия боли, депрессии, беспокойства и других состояний здоровья, вы не заслуживаете положительного результата теста на наркотики.
Вы можете ограничить риск получения «ложного срабатывания», покупая продукты CBD только в надежных компаний. Не выбирайте дешевые продукты CBD, потому что есть вероятность; они содержат THC и другие химические вещества. Изучите продукт, который вы покупаете, и убедитесь, что он содержит нужное количество THC. Убедитесь, что продукт был протестирован сторонней лабораторией и имеет сертификат анализа (COA), аккредитованный товаром. Он должен иметь сертификат анализа (COA), выданный лабораториями, сертифицированными одной из этих организаций: Ассоциацией официальных сельскохозяйственных химиков (AOAC), Американской фармакопеей трав (AHP) или Фармакопеей США (USP).
CBD предлагает отличные медицинские преимущества, и вам не следует кататься на коньках по тонкому льду, покупать дешевые CBD и проваливать тест на наркотики.